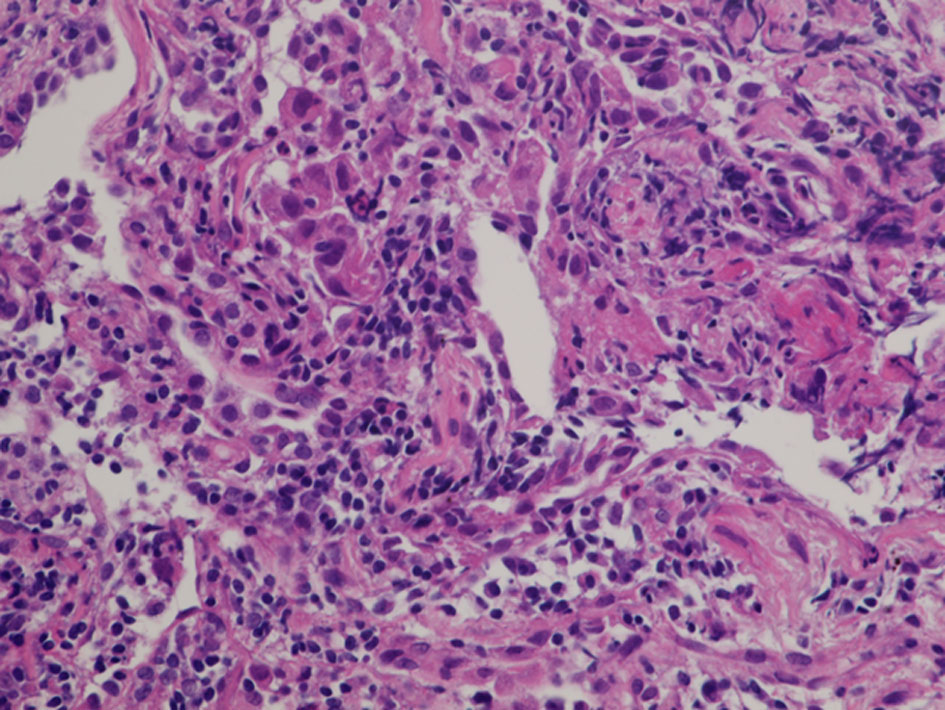

| World Journal of Oncology, ISSN 1920-4531 print, 1920-454X online, Open Access |
| Article copyright, the authors; Journal compilation copyright, World J Oncol and Elmer Press Inc |
| Journal website https://www.wjon.org |
Case Report
Volume 14, Number 1, February 2023, pages 101-107
Long-Term Responders to Erlotinib for Pulmonary Adenocarcinoma With Wild-Type Epidermal Growth Factor Receptor: Two Case Reports and a Single-Institutional Retrospective Study
Seigo Minamia, b, Nao Shoshiharaa
aDepartment of Respiratory Medicine, Osaka Police Hospital, Osaka, Japan
bCorresponding Author: Seigo Minami, Department of Respiratory Medicine, Osaka Police Hospital, 10-31 Kitayama-cho, Tennoji-ku, Osaka-City, Osaka 543-0035, Japan
Manuscript submitted December 10, 2022, accepted January 26, 2023, published online February 26, 2023
Short title: Erlotinib for Wild-Type EGFR
doi: https://doi.org/10.14740/wjon1554
- Abstract
- Introduction
- Patients’ Inclusion
- Data Analyses
- Retrospective Study
- Case Reports
- Discussion
- References
| Abstract | ▴Top |
Erlotinib is an oral and reversible epidermal growth factor receptor (EGFR) tyrosine kinase inhibitor and is now used exclusively to non-small cell lung carcinoma (NSCLC) harboring mutated EGFR. However, there was historically a transient period when erlotinib was widely used regardless of EGFR mutation status. We report two cases with adenocarcinoma and wild-type EGFR status, which responded to erlotinib for unusual long time. We also retrospectively analyzed patients with adenocarcinoma and wild-type EGFR mutation status who had received erlotinib-containing regimen in our hospital. A 60-year-old woman received the second-line and tri-weekly regimen of pemetrexed (500 mg/m2 on day 1) and intermittent erlotinib (150 mg on days 2 - 16). Pemetexed was discontinued 18 months after the initiation of this regimen, but erlotinib was continued for more than 11 years. This chemotherapy successfully reduced her brain metastasis and prevented recurrence. A 58-year-old man received erlotinib monotherapy as the third-line regimen, by which multiple brain metastases disappeared. Although we tried stopping erlotinib 9 years after the initiation of erlotinib, a solitary metastasis appeared in the brain 3 months after the discontinuation of erlotinib. Between December 2007 and October 2015, 39 patients with wild-type EGFR status initiated erlotinib-containing regimens at our hospital. The response rate, progression-free survival and overall survival were 17.9% (95% confidence interval (CI): 7.5-33.5%), 2.7 months (95% CI: 1.8 - 5.0 months) and 10.3 months (95% CI: 5.0 - 15.7 months), respectively. We reported two long-term responders and survivors to erlotinib for more than 9 years, which was much longer than patients with adenocarcinoma and wild-type EGFR mutation status who had received erlotinib-containing regimen in our hospital.
Keywords: Erlotinib; Wild-type epidermal growth factor receptor mutation status; EGFR Tyrosine kinase inhibitor; Adenocarcinoma; Non-small cell lung carcinoma; Responder; Survivor
| Introduction | ▴Top |
Erlotinib, an oral and reversible epidermal growth factor receptor (EGFR) tyrosine kinase inhibitor (TKI), has been established as the first-line regimen for patients with EGFR mutation positive non-small cell lung carcinoma (NSCLC). For chemo-naive patients with mutated EGFR, erlotinib provided 9.7 to 13.1 months of median progression-free survival (PFS) and 19.3 to 22.8 months of median overall survival (OS) [1-3].
In advance of evidences for mutated EGFR, for NSCLC patients irrespective of EGFR mutation status, this drug had been already demonstrated to improve both PFS and OS in the second or later line setting [4] and to prolong PFS in the maintenance after the first-line platinum-doublet chemotherapy [5]. Thus, erlotinib was approved in November 2004 by the US Food and Drug Administration (FDA), and then in October 2007 by Japanese medical insurance for the treatment of inoperable NSCLC that has failed at least one prior chemotherapy regimen, irrespectively of EGFR mutation status. EGFR mutation tests already became covered by Japanese medical insurance in June 2007. However, erlotinib was obviously inferior to docetaxel in second- or third-line treatment for pre-treated patients with NSCLC who had wild-type EGFR tumors. For patients with wild-type EGFR status, erlotinib provided only 1.3 to 2.4 months of median PFS and 5.4 to 9.0 months of median OS [6, 7]. Thus, there was historically a transient period when erlotinib was widely used regardless of EGFR mutation status, while this drug is now exclusively limited to NSCLC harboring mutated EGFR.
Herein, we report two long-term responders to erlotinib, and retrospectively analyzed patients with adenocarcinoma and wild-type EGFR mutation status who had received erlotinib-containing regimen in our hospital.
| Patients’ Inclusion | ▴Top |
This study retrospectively collected 39 patients. The inclusion criteria were as follows: 1) cytologically or histologically adenocarcinoma; 2) wild-type EGFR confirmed by LSI Medience Cooperation (Tokyo, Japan) using the peptide nucleic acid-locked nucleic acid PCR clamp method; 3) clinical stage IIIB or IV in the seventh lung cancer TNM classification and staging system published by the International Union Against Cancer (UICC); and 4) treated with erlotinib-containing regimen at our hospital. We collected the following pretreatment backgrounds and treatment results: sex, age, smoking history, cancer pathological type, EGFR mutation status, Eastern Cooperative Oncology Group (ECOG) performance status (PS), metastatic sites, previous regimens, treatment response according to the Response Evaluation Criteria in Solid Tumors (RECIST) version 1.1, PFS, OS, 1-year PFS and OS rates. PFS and OS were defined as the intervals between the first day of erlotinib and documented progressive disease (PD) or death, and death due to any causes, respectively. Response and disease control rates (RR and DCR) were the rates of complete and partial responses (CR and PR), and CR to stable disease (SD) in all patients, respectively. The data were cut-off by October 30, 2022. Our study was approved by the Osaka Police Hospital Ethics Committee, and followed STROBE statement.
| Data Analyses | ▴Top |
The continuous, categorical and survival data were shown by median value with range, frequencies, median time (months) with 95% confidence intervals (CIs) and Kaplan-Meier method, respectively. We compared OS and PFS by the log-rank test. A P-value < 0.05 was defined as statistically significant. We conducted all statistical analyses by EZR (Saitama Medical Center, Jichi Medical University, Saitama, Japan), which is a graphical user interface for R (The R Foundation for Statistical Computing, Vienna, Austria) [8].
| Retrospective Study | ▴Top |
Between December 2007 and October 2015, 39 patients with wild-type EGFR status initiated either erlotinib monotherapy (N = 19) or erlotinib-containing combination regimens (N = 20) at our hospital (Fig. 1). Clinical backgrounds and treatments of the 39 patients are listed in Table 1. Two and five patients achieved CR and PR, respectively. Ten maintained SD, and 21 had PD. Two patients (cases 1 and 2, described below) were still alive at the time of analysis, 36 died and one lost follow-up. The RR, DCR, PFS, OS, 1-year PFS and OS rates were 17.9% (95% CI: 7.5-33.5%), 43.6% (27.8-60.4%), median 2.7 months (1.8 - 5.0 months) (Fig. 2a), median 10.3 months (5.0 - 15.7 months) (Fig. 2b), 8.4% (2.2-20.2%) and 48.3% (31.9-62.8%), respectively. Comparing combination chemotherapy (N = 19) with monotherapy (N = 20), both median PFS (combination 4.9 months vs. monotherapy 1.8 months, P = 0.09) and OS (15.6 vs. 5.0 months, P = 0.055) of combination regimens were longer than those of monotherapy (Fig. 3). However, there were not statistically significant differences between two treatment styles.
![]() Click for large image | Figure 1. Patients’ selection. |
![]() Click to view | Table 1. Patient’s Characteristics and Treatment (N = 39) |
![]() Click for large image | Figure 2. Kaplan-Meier curves of progression-free survival (a) and overall survival (b) of all patients (N = 39). |
![]() Click for large image | Figure 3. Kaplan-Meier curves of progression-free survival (a) and overall survival (b) based on monotherapy (N = 20) and combination (N = 19). |
| Case Reports | ▴Top |
Case 1
A 60-year-old woman was referred to our department because of a tumor shadow in the left middle lung field in November 2008. She had stopped smoking 5 years before, and was an ex-smoker with 30 pack-year smoking history. She had no significant medical history except for hyperlipidemia. Whole body computed tomography (CT) revealed a 29 × 27 mm sized tumor in the left S4 without distant metastasis. She was diagnosed as lung adenocarcinoma by bronchoscopy from left B4 (Fig. 4). She underwent left upper lobe resection and mediastinal lymph node dissection in December 2008. The pathological staging was p-stage IA (p-T1bN0M0). On genetic examination, no EGFR mutation was detected by PCR clamp method from the surgical specimen. In November 2010, 22 months after the surgery, she visited to our emergency room and presented paralyzed left hand. Brain CT with contrast enhancement revealed a 16 × 13 mm sized tumor with surrounding edema in the right frontal lobe (Fig. 5a). No other distant metastasis was found at that time. We suspected a solitary brain metastasis from lung cancer. She underwent gamma knife radiosurgery (GKR) at another hospital. In August 2011, 10 months after the first GKR, she again received the second GKR for the recurrence at the same brain metastatic site. Thereafter, despite of two courses of carboplatin (area under the curve (AUC) 6 mg/mL/min, day 1) and weekly paclitaxel (60 mg/m2, days 1, 8 and 15), the brain metastasis regrew (Fig. 5b). We started tri-weekly combination chemotherapy of pemetrexed (500 mg/m2, day 1) and intermittent erlotinib (150 mg, days 2 - 16) in November 2011 [9, 10], which reduced the brain metastasis (Fig. 5c). Pemetrexed was discontinued due to grade 3 of edema on the extremities in June 2013, after 28 courses. She continued 150 mg/day of erlotinib, and experienced neither progression nor severe adverse events in October 2022, 11 years after erlotinib initiation. After the initiation of pemetrexed and erlotinib, the Vysis Break Apart ALK fluorescence in situ hybridization (FISH) assay (by LSI Medience Corporation, Tokyo), approved by Japanese medical insurance in April 2012, detected ALK rearrangement in the surgical specimen.
![]() Click for large image | Figure 4. Histology of bronchoscopical specimen of case 1 (H&E stain). H&E: hematoxylin and eosin. |
![]() Click for large image | Figure 5. Brain metastasis of case 1. (a) Postoperative recurrence in November 2010. (b) Before (in October 2011) and (c) 1 year after (in October 2012) the initiation of pemetrexed and erlotinib. Yellow arrows show the brain metastases. |
Case 2
A 58-year-old man was referred to our department because of a tumor shadow in the right middle lung field in April 2010, and presented with a 2-month history of intermittent bloody sputum. He was an ex-smoker with 35 pack-year smoking history, and had no significant medical history except for hypertension. Chest CT showed an 80 × 40 mm sized sub-pleural tumor and multiple intrapulmonary nodules in the right lung. The right hilar, mediastinal and supraclavicular lymph nodes were swollen. He was diagnosed as lung adenocarcinoma by bronchoscopical biopsy from the right B3b (Fig. 6). The clinical stage was c-stage IIIB (cT3N3M0). No EGFR mutation was found in the bronchoscopical specimen by PCR clamp method. Because of the tiny residual specimen, neither ALK nor other mutation could not be examined. The first-line chemotherapy of four courses of induction carboplatin (AUC 6 mg/mL/min, day 1) and pemetrexed (500 mg/m2, day 1) provided PR, but the following two courses of pemetrexed maintenance resulted in progression of the primary tumor, intrapulmonary metastases and multiple mediastinal lymphadenopathies. The second-line of docetaxel (60 mg/m2, day 1) achieved PR temporarily. However, 2 months after the completion of four courses of docetaxel, multiple brain metastases appeared (Fig. 7a, b). Theses metastases successfully disappeared by erlotinib (150 mg/day, every day), which was initiated as the third-line chemotherapy in March 2011 (Fig. 7c, d). Erlotinib was reduced to 100 mg/day in March 2013 because of progressive polymyalgia, which might be retrospectively a prodromal symptom of polycythemia vera. We tried stopping erlotinib in March 2020, because no recurrence had been found for 9 years after the initiation of erlotinib. However, 3 months after the discontinuation of erlotinib, a solitary metastasis appeared in the left temporal lobe (Fig. 7e). He received GKR at another hospital in July 2020, and then resumed erlotinib in August 2020. Hydroxycarbamide (500 mg/day, 3 days/week) was started by hematologists in October 2020 for polycythemia vera harboring JAK2V617 mutation, when peripheral leukocyte count was continuously over 70,000 cells/µL. Thereafter, he continued combination of hydroxycarbamide and erlotinib, and no recurrence of lung cancer had been found in October 2022, 11 years and 8 months after the start of erlotinib. He experienced grade 4 of retroperitoneal hemorrhage in January 2020, grade 3 of intramuscular hematoma in the left femoral muscle in May 2015, grade 2 of skin hyperpigmentation, paronychia and multiple compression fractures.
![]() Click for large image | Figure 6. Histology of bronchoscopical specimen of case 2 (H&E stain). H&E: hematoxylin and eosin. |
![]() Click for large image | Figure 7. Brain metastases of case 2. Before (in March 2011) (a, b) and 3 months after (in June 2011) (c, d) the initiation of erlotinib monotherapy. (e) Appearance of the left temporal metastasis 3 months after the discontinuation of erlotinib. Yellow arrows show the brain metastases. |
| Discussion | ▴Top |
To our knowledge, there was no report such as our unusually long-term responders and survivors of NSCLC with wild-type EGFR mutation status treated by erlotinib or other EGFR-TKIs.
We do not know why erlotinib successfully maintained an unusual long response in our cases. Compared with our previous patients with wild-type EGFR treated with erlotinib, these two cases kept response to erlotinib and survived for much longer time. Although the case 1 patient had ALK rearrangement and initially received 28 courses of pemetrexed, erlotinib monotherapy kept CR for more than 9 years after the discontinuation of pemetrexed. For ALK-positive patients who had received platinum-based regimen, median PFS and OS were only 4.2 months with pemetrexed and 22.8 months with chemotherapy of pemetrexed or docetaxel, respectively [11]. Thus, erlotinib, rather than pemetrexed, contributed to such a long response. In case 2, a brain metastasis was brought by only 3 months suspension of erlotinib, after 9 years of the continuous administration of erlotinib. This phenomenon in case 2 suggested that the long effect of erlotinib was mainly cytotoxic, but was different from immunological, such as abscopal effect, a systemic anticancer response after radiation therapy. Thus, the cytotoxic effect of erlotinib which maintained over a long time might have contributed to our cases.
Our reports have several limitations. First, we are unable to examine comprehensive genetic and immunological profiles. Our cases were diagnosed more than 10 years before, and have no cancer lesion from which we can obtain sufficient sample. We did not try liquid biopsy of EGFR mutation. We do not save the old samples. Second, our sample size was small and single-institutional analysis might contain some bias. Currently, erlotinib is difficult to be selected for wild-type EGFR status. Thus, our rare clinical course is impossible to be prospectively investigated on a large scale.
Conclusions
We reported two long-term responders and survivors to erlotinib, which was much longer than patients with adenocarcinoma and wild-type EGFR mutation status who had received erlotinib-containing regimen in our hospital.
Acknowledgments
None to declare.
Financial Disclosure
None to declare.
Conflict of Interest
None to declare.
Informed Consent
The patients have given written informed consent for publication of this case report, including the accompanying images. The Ethics Committee of Osaka Police Hospital approved our study.
Author Contributions
All authors were involved in diagnosis and treatment of this patients. Minami S drafted the report. All authors read and critically reviewed the manuscript, and then approved the final submitted version.
Data Availability
The authors declare that data supporting the findings of this study are available within the article.
Abbreviations
AUC: area under the curve; CI: confidence interval; CR: complete response; CT: computed tomography; DCR: disease control rate; ECOG-PS: Eastern Cooperative Oncology Group performance status; EGFR: epidermal growth factor receptor; GKR: gamma knife radiosurgery; NSCLC: non-small cell lung carcinoma; OS: overall survival; PD: progressive disease; PFS: progression-free survival; PR: partial response; RECIST: Response Evaluation Criteria in Solid Tumors; RR: response rate; SD: stable disease; TKI: tyrosine kinase inhibitor
| References | ▴Top |
- Zhou C, Wu YL, Chen G, Feng J, Liu XQ, Wang C, Zhang S, et al. Final overall survival results from a randomised, phase III study of erlotinib versus chemotherapy as first-line treatment of EGFR mutation-positive advanced non-small-cell lung cancer (OPTIMAL, CTONG-0802). Ann Oncol. 2015;26(9):1877-1883.
doi pubmed - Rosell R, Carcereny E, Gervais R, Vergnenegre A, Massuti B, Felip E, Palmero R, et al. Erlotinib versus standard chemotherapy as first-line treatment for European patients with advanced EGFR mutation-positive non-small-cell lung cancer (EURTAC): a multicentre, open-label, randomised phase 3 trial. Lancet Oncol. 2012;13(3):239-246.
doi pubmed - Zhou C, Wu YL, Chen G, Feng J, Liu XQ, Wang C, Zhang S, et al. Erlotinib versus chemotherapy as first-line treatment for patients with advanced EGFR mutation-positive non-small-cell lung cancer (OPTIMAL, CTONG-0802): a multicentre, open-label, randomised, phase 3 study. Lancet Oncol. 2011;12(8):735-742.
doi pubmed - Shepherd FA, Rodrigues Pereira J, Ciuleanu T, Tan EH, Hirsh V, Thongprasert S, Campos D, et al. Erlotinib in previously treated non-small-cell lung cancer. N Engl J Med. 2005;353(2):123-132.
doi pubmed - Cappuzzo F, Ciuleanu T, Stelmakh L, Cicenas S, Szczesna A, Juhasz E, Esteban E, et al. Erlotinib as maintenance treatment in advanced non-small-cell lung cancer: a multicentre, randomised, placebo-controlled phase 3 study. Lancet Oncol. 2010;11(6):521-529.
doi pubmed - Kawaguchi T, Ando M, Asami K, Okano Y, Fukuda M, Nakagawa H, Ibata H, et al. Randomized phase III trial of erlotinib versus docetaxel as second- or third-line therapy in patients with advanced non-small-cell lung cancer: Docetaxel and Erlotinib Lung Cancer Trial (DELTA). J Clin Oncol. 2014;32(18):1902-1908.
doi pubmed - Garassino MC, Martelli O, Broggini M, Farina G, Veronese S, Rulli E, Bianchi F, et al. Erlotinib versus docetaxel as second-line treatment of patients with advanced non-small-cell lung cancer and wild-type EGFR tumours (TAILOR): a randomised controlled trial. Lancet Oncol. 2013;14(10):981-988.
doi pubmed - Kanda Y. Investigation of the freely available easy-to-use software 'EZR' for medical statistics. Bone Marrow Transplant. 2013;48(3):452-458.
doi pubmed - Minami S, Kijima T, Hamaguchi M, Nakatani T, Koba T, Takahashi R, Takeuchi Y, et al. Phase II study of pemetrexed plus intermittent erlotinib combination therapy for pretreated advanced non-squamous non-small cell lung cancer with documentation of epidermal growth factor receptor mutation status. Lung Cancer. 2013;82(2):271-275.
doi pubmed - Minami S, Kijima T, Takahashi R, Kida H, Nakatani T, Hamaguchi M, Takeuchi Y, et al. Combination chemotherapy with intermittent erlotinib and pemetrexed for pretreated patients with advanced non-small cell lung cancer: a phase I dose-finding study. BMC Cancer. 2012;12:296.
doi pubmed - Shaw AT, Kim DW, Nakagawa K, Seto T, Crino L, Ahn MJ, De Pas T, et al. Crizotinib versus chemotherapy in advanced ALK-positive lung cancer. N Engl J Med. 2013;368(25):2385-2394.
doi pubmed
This article is distributed under the terms of the Creative Commons Attribution Non-Commercial 4.0 International License, which permits unrestricted non-commercial use, distribution, and reproduction in any medium, provided the original work is properly cited.
World Journal of Oncology is published by Elmer Press Inc.